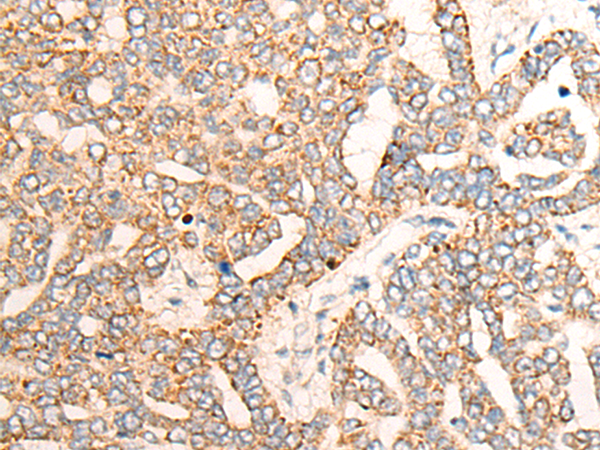
一抗

中文名稱: 兔抗PPM1D多克隆抗體
英文名稱: Anti-PPM1D rabbit polyclonal antibody
別 名: protein phosphatase, Mg2+/Mn2+ dependent 1D WIP1; PP2C-DELTA
抗 原: PPM1D
儲(chǔ) 存: 冷凍(-20℃)
宿 主: Rabbit
相關(guān)類別: 一抗
反應(yīng)種屬: Human, Mouse
標(biāo) 記 物: Unconjugate
克隆類型: rabbit polyclonal
技術(shù)規(guī)格
|
Background: |
The protein encoded by this gene is a member of the PP2C family of Ser/Thr protein phosphatases. PP2C family members are known to be negative regulators of cell stress response pathways. The expression of this gene is induced in a p53-dependent manner in response to various environmental stresses. While being induced by tumor suppressor protein TP53/p53, this phosphatase negatively regulates the activity of p38 MAP kinase, MAPK/p38, through which it reduces the phosphorylation of p53, and in turn suppresses p53-mediated transcription and apoptosis. This phosphatase thus mediates a feedback regulation of p38-p53 signaling that contributes to growth inhibition and the suppression of stress induced apoptosis. This gene is located in a chromosomal region known to be amplified in breast cancer. The amplification of this gene has been detected in both breast cancer cell line and primary breast tumors, which suggests a role of this gene in cancer development. |
|
Applications: |
ELISA, WB, IHC |
|
Name of antibody: |
PPM1D |
|
Immunogen: |
Fusion protein of human PPM1D |
|
Full name: |
protein phosphatase, Mg2+/Mn2+ dependent 1D |
|
Synonyms: |
WIP1; PP2C-DELTA |
|
SwissProt: |
O15297 |
|
ELISA Recommended dilution: |
2000-5000 |
|
IHC positive control: |
Human liver cancer and Human esophagus cancer |
|
IHC Recommend dilution: |
40-200 |
|
WB Predicted band size: |
67 kDa |
|
WB Positive control: |
Human placenta tissue lysate |
|
WB Recommended dilution: |
200-1000 |



 購物車
購物車 幫助
幫助
 021-54845833/15800441009
021-54845833/15800441009